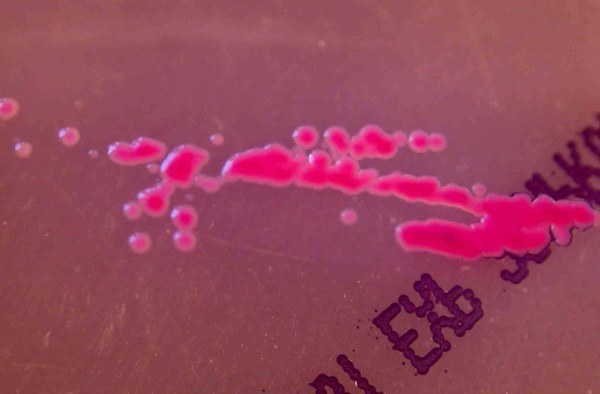
Salmonellenwachstum auf Nährboden

Hygiene
Wer für Lebensmittel und Gebrauchsgegenstände verantwortlich ist muss dafür sorgen, dass diese nicht durch Mikroorganismen und Fremdstoffe oder auf andere Weise nachteilig verändert werden. Es sind alle Massnahmen und Vorkehrungen zu treffen die notwendig sind, um eine Gefahr für den Menschen unter Kontrolle zu bringen und zu gewährleisten, dass ein Lebensmittel bei vorgesehener Verwendung für den menschlichen Konsum geeignet ist. Dazu gehört, dass auch Gefässe. Apparate, Werkzeuge, Packmaterial, Transportmittel usw. sowie die zur Herstellung, zur Aufbewahrung und zum Verkauf von Lebensmitteln benützten Räume sauber und in gutem Zustand sind. Die Ausführungsbestimmungen dazu, sowie Grenz- und Toleranzwerte von Mikroorganismen für Produkte und Produktegruppen, sind in der Hygieneverordnung festgehalten.
Downloads
| Typ | Titel | Dokumentart |
|---|---|---|
| Lebensmittel: Hygienischer Umgang im Privathaushalt | Informationsblatt | |
| Lebensmittel: Umgang mit rohem Fleisch im Privathaushalt | Informationsblatt | |
| Verbrauchertipps: Schutz vor Lebensmittelinfektionen im Privathaushalt | Informationsblatt |